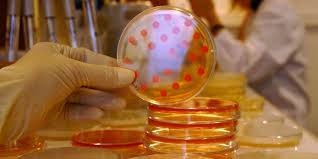

Dans le cadre de la réévaluation du rapport bénéfice-sécurité d'emploi des pénicillines du groupe M, l'Agence français de securité sanitaire des produits de santé (AFSSPS) a pris les décisions suivantes, à savoir le retrait du marché de spécialités à base d’oxacilline orale et la suppression du recours à la voie intra-musculaire des spécialités à base d’oxacilline et de cloxacilline à compter du 23 mai 2011.
Il a aussi été décidé le maintien de la voie intraveineuse pour l’oxacilline et la cloxacilline, avec révision de leur schéma posologique et la cloxacilline par voie orale, uniquement dans le traitement des infections cutanées peu sévères Il a en effet été démontré que les recommandations posologiques actuelles exposaient à des sous-dosages avec risques d'échecs, notamment pour les infections potentiellement graves tout en favorisant l'antibiorésistance.
Pour obtenir le niveau de concentration d’antibiotique requis pour être efficace dans le traitement des infections considérées, des augmentations posologiques étaient nécessaires.Compte tenu des spécificités pharmacocinétiques, des spécialités disponibles et des contraintes liées aux voies d’administration n’ont pas pu être possibles dans toutes les situations.
L’Afssaps annonce aussi sur son site internet qu’elle a jugé le bénéfice/risque de l’oxacilline par voie orale et de la cloxacilline par voie intraveineuse défavorable du fait de leur efficacité jugée insuffisante et a donc retiré les autorisations de mise sur le marché des spécialités correspondantes.
L’Afssaps précise qu’elle a pris les décisions suivantes dans le cadrede la réévaluation du rapport bénéfice-sécurité d’emploi despénicillines du groupe M.
Il a donc été décidé le retrait du marché de spécialités à base d’oxacilline orale et suppression du recours à la voie intra-musculaire des spécialités à base d’oxacilline et de cloxacilline à compter du 23 mai 2011 Par contre, il est question du maintien de la voie intraveineuse pour l’oxacilline et la cloxacilline, avec révision de leur schéma posologique et la cloxacilline par voie orale, uniquement dans le traitement des infections cutanées peu sévères.
« Il a en effet été démontré que les recommandations posologiques actuelles exposaient à des sous- dosages avec risques d’échecs, notamment pour les infections potentiellement graves tout en favorisant l’antibiorésistance », lit-on dans le rapport.Pour obtenir le niveau de concentration d’antibiotique requis pour être efficace dans le traitement des infections considérées, des augmentations posologiques étaient nécessaires.
Compte tenu des spécificités pharmacocinétiques des spécialités disponibles et des contraintes liées aux voies d’administration, elles n’ont pas pu être possibles dans toutes les situations »; précise enfin l’autorité sanitaire.















